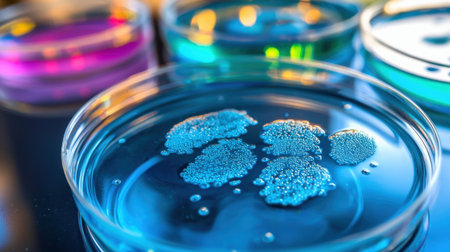
A close-up of a petri dish with blue bacteria culture, representing scientific researchの素材

素材 - A close-up of a petri dish with blue bacteria culture, representing scientific research
作品情報
A close-up of a petri dish with blue bacteria culture, representing scientific research
- ID:253819931
- 作品種別:
- 作者名:Kanyarat Phuphaphan
キーワード
- analysis
- analyzing
- background
- bacterium
- biochemistry
- biology
- biotechnology
- blue
- chemical
- chemistry
- close-up
- closeup
- color image
- detailed
- discovery
- dish
- dna
- earth
- equipment
- experiment
- extreme close-up
- genetic
- genetic research
- glass - material
- healthcare and medicine
- horizontal
- innovation
- laboratory
- laboratory equipment
- laboratory glassware
- liquid
- macro
- macrophotography
- medical research
- medicine
- microbiology
- microscopic
- no people
- petri
- petri dish
- research
- science
- scientific experiment
- scientist
- specimen holder
- technology
- transparent
- water
類似作品
Woman at the ta...
A close-up shot...
Delicate steam ...
This vibrant im...
Volunteer conce...
A man is cookin...
Close-up of fem...
person, making ...
Pasta with meat...
charity food fo...
A beautifully p...
Waiter carrying...
Free food for t...
A street vendor...
A person scoopi...
Cheese soup in ...
Stunning modern...
A sizzling plat...
Female hands ho...
concept of char...
The wealthy ric...
Professional Ch...
Helping Feed th...
The hand of the...
Professional ch...
Papaya salad
There is a sala...
A chef in a res...
Wok Filled With...
Beautiful happy...
warm gathering ...
Hand-feeding to...
Providing free ...
cooking in the ...
Helping the poo...
Hands with a wh...
The concept of ...
Close up to del...
A dynamic shot ...
Woman eating om...
Close-up of bub...
Cooking, restau...
Serving food in...
Blurred of suki...
A Warm Meal on ...
A frying pan fi...
The concept of ...
A dynamic scene...
chef at work